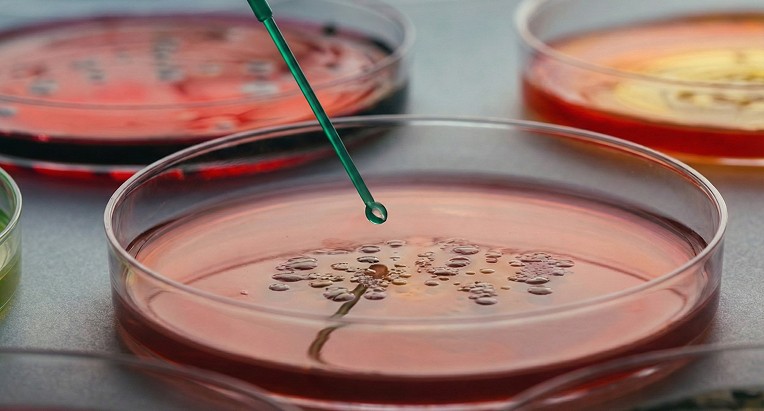

Meet Your Inner Power Plants
Mitochondria, the tiny engines powering every cell in your body. Your energy, resilience, and longevity depend on them.
Mitochondria are the powerhouse of your cells









How it works
When they falter,
energy drops
clarity fades
recovery slows
Evidence-led. Practitioner-proven.
Map Pathways first
1
1
We begin by mapping five interconnected pathways - mitochondrial output, NAD+ repair, redox balance, methylation, and fuel utilization - to see where support matters most.
Select Actives
We choose clinically studied ingredients in transparent doses that fit each pathway’s specific role.
2
2


3
3
Refine Evidence
As new human data appears, we adjust doses and ratios so the formula evolves with the science.
Verify Batches
Core100 is made in a U.S. cGMP facility, and every lot is confirmed for identity, potency, and purity by independent third-party labs.
4
4

Ingredients for cellular repair
4x stronger antioxidant activity
Y100 shows 4x the activity of CoQ10 and Vitamin E in clinical studies.
Mitochondrial renewal
Increases mitochondrial markers (SIRT3, TFAM, PGC-1a) within 6-24 hours.
Clinically validated ingredients
Demonstrated improvements in markers of mitochondrial function, oxidative stress, and exercise capacity
Measured results from the ingredients powering Core100
NAD⁺ increase
38% in 8 weeks (human trial, NR/NMN)
Inflammation biomarkers (CRP, MDA)
20-35%
VO₂ Max
12%
Muscle endurance
18%
ATP production
38%
*Results from clinical studies on Y100.
Individual results may vary.


